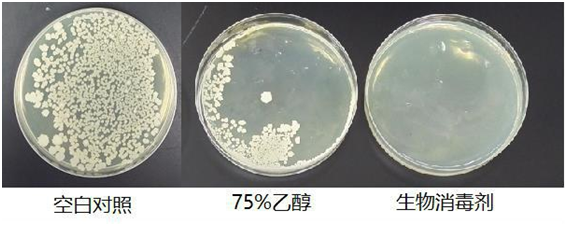

本产品是由酒精、蔗糖脂肪酸酯、酸度调节剂等产品经过独特的精制,纯化,复配工艺而生产的天然生物型消毒剂,不含任何化工类合成原料,天然健康,亦可作为食品添加剂用于食品及食品添加剂的生产工艺中。
用途:
食品加工设备、器具及车间消毒
食品加工人员手部的杀菌消毒
食品表面喷洒或者浸泡
使用方法:
将食品机械,管道等适用对象的表面进行清洗后,对表面进行喷雾处理至表面湿润状,也可进行浸泡处理。(喷雾处理后无需进行再次清洗)
对待加工食品,进行喷雾,或者配料加入/浸泡处理,推荐使用量 1%。
产品性状规格:
产品性状为无色透明液体,25L/桶
保存方法及日期:
避免日光直射、常温低湿度处密封保存。
保质期为制造后 24 个月。
产品对比:
|
产品名称 |
优势 |
劣势 |
|
TM124 |
u 广谱抑菌,有效抑制空气中各种细菌(对革兰氏阴性菌和阳性菌都有抑制作用)、真菌、病原微生物等 u 高效持久(抑菌能力为75%酒精的100倍) u 对人体无影响,可直接接触食品
|
u 需连续使用20-25天效果更佳明显 |
|
75%酒精 |
u 使用范围广 u 浓度越高,抑菌效果越好 |
u 稳定性差,易挥发 u 浓度低抑菌效果差,浓度过高对人体造成伤害 |
|
次氯酸钠 |
u 高效抑菌 |
u 气味刺鼻,对人体有损伤 u 稳定性差,易分解 u 作用时间短 |
|
臭氧 |
u 广谱高效 u 目前车间消毒使用广泛 |
u 臭氧对人体呼吸道粘膜有刺激,消毒时不可有人 u 臭氧为强氧化剂,对器具有腐蚀作用 u 稳定性较差 |
注意事项:
开封后,密封保存,尽早使用。
可能有沉淀形成,但对使用性能和品质无影响。